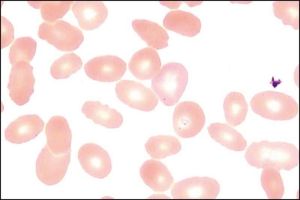
Wegener肉芽腫

流行病學
 Wegener肉芽腫
Wegener肉芽腫Wegner肉芽腫多呈散發性,無任何固定的時間聚集性或遺傳模式。Raynauld等發現症狀的出現有季節性變化,高峰在春季,低谷在夏季。支持Wegener肉芽腫有遺傳傾向性的資料很少美國國立衛生研究院(NIH)對158例Wegner肉芽腫患者的研究顯示其平均年齡在41歲(範圍9~78歲),包括兒童和成年Wegner肉芽腫患者,其中15%的患者在20歲前發病高發年齡40~50歲,男∶女比例為2∶1。兒童的發病情況與成人相似,但兒童的軟骨結構更易受到損傷。兒童的鼻畸形發生率是成人的2倍,聲門下狹窄是成人的5倍。Cotch等進行的回顧性研究發現3%的Wegner肉芽腫住院患者小於20歲,74%超過45歲,估計每10年死於Wegner肉芽腫的人數大約為2240人。
病因
雖然關於Wegner肉芽腫的病因學和免疫學已有大量的研究資料,但許多詳細環節還不清楚。長期以來人們懷疑感染因素是引起Wegner肉芽腫的病因。在尋找病因時人們使用了多種有效的新技術,但前景並不樂觀有人推測此病的病因可能與病毒感染有關。然而分子生物學和血清學方面並未發現有病毒感染的證據。有證據表明普通的感染也可使Wegner肉芽腫復發,但這一效應屬非特異性,與疾病的原發病因無關。
自從發現抗中性粒細胞胞漿自身抗體(antineutrophil cytoplasmic antibodies,ANCA)與Wegner肉芽腫之間有相關性後,人們對Wegner肉芽腫發病機制的研究興趣明顯增加。雖然沒有直接證據表明ANCA可引起Wegner肉芽腫,但間接的證據越來越多。缺乏切實可行的Wegner肉芽腫動物模型已成為研究其發病機制的主要障礙。
發病機制
 T細胞
T細胞血管壁上具有免疫球蛋白和補體,這為免疫複合物在原發性血管炎的發病過程中起一定作用提供了間接的證據免疫複合物形成並結合於內皮細胞可以啟動補體級聯反應,釋放炎症介質。血管壁壞死是免疫複合物損傷常見的組織學改變,這可通過核碎片(如白細胞破碎)和外滲的紅細胞加以識別然而伴隨這種血管損傷的白細胞破碎形式並不是免疫複合物介導的疾病所特有的。
抗內皮細胞抗體抗膠原和基質蛋白抗體可通過抗體依賴細胞介導的細胞毒作用損傷血管。因為低於20%的Wegner肉芽腫患者具有抗內皮細胞抗體,所以這種損傷類型可能並不是引起原發性疾病過程的關鍵環節。
細胞介導的損傷可導致形成富含T細胞和巨噬細胞的肉芽腫,這可能是原發性血管炎不常見的機制細胞介導的損傷通常發生於血管移植的同種異體排斥反應、巨細胞動脈炎和Takayasu動脈炎中。在Wegner肉芽腫中,細胞介導的發病過程在軟組織損傷中的作用可能比在血管損傷中的作用大。
繼發性血管炎是指由其他疾病引起的血管炎感染性疾病是繼發性血管炎最常見的病因。多種感染因素可損傷血管組織,包括人類免疫缺陷病毒(human immunodeficiency virus,HIV)、皰疹病毒家族、螺鏇體立克次體、支原體和B肝病毒。繼發性血管炎的發病機制根據不同的病因而與原發性血管炎有所不同例如感染性血管炎的組織損傷,通常是由微生物侵襲內皮細胞所引起的繼而啟動中性粒細胞的趨化反應產生免疫複合物。
臨床表現
 視網膜
視網膜眼部表現包括嚴重的眼眶假瘤、眼眶膿腫、蜂窩織炎或者鼻淚管阻塞,其中眼眶炎症伴眼球突出是Wegner肉芽腫最常見的眼部表現。結膜炎、鞏膜炎、鞏膜外層炎和角膜炎比較常見也可見缺血性視神經病變、視網膜動脈阻塞、葡萄膜炎、視網膜缺血等病變。
壞死性鞏膜炎和周邊潰瘍性角膜炎是Wegner肉芽腫的惡性程度最高的臨床表現,兩者可導致眼穿孔而致盲,甚至喪失眼球,患者數占Wegner肉芽腫的12%~13%。在早期的體格檢查中,Wegner肉芽腫患者均可出現鞏膜炎鞏膜炎常與全身症狀相平行,可能是全身性疾病惡化的早期表現周邊潰瘍性角膜炎較常見,常為雙側性的。多由角鞏膜緣的浸潤開始,進而導致上皮和基質的壞死和潰瘍。潰瘍可向中央和周圍發展。Wegner肉芽腫的鞏膜外層炎比鞏膜炎少見。鞏膜外層炎可分為單純型或結節型,常易復發。可以是患者就診的首發症狀。
眼眶假瘤或眼眶炎症伴眼球突出者較常見。22%的Wegner肉芽腫患者具有該種臨床表現,有眼部症狀的Wegner肉芽腫患者中45%具有此種症狀。此類患者中50%的眼眶活檢顯示典型的肉芽腫炎症組織壞死和血管炎。
大約8%的Wegner肉芽腫患者視力喪失。視力喪失通常是雙側性的,這是由Wegner肉芽腫的全身性病變所決定,但雙眼的受累情況常不對稱。視力下降的機制很多,包括血管閉塞、黃斑水腫、眼神經感覺組織的炎症性破壞和結構性組織的破壞。Wegner肉芽腫的常見眼部表現。
診斷
Wegner肉芽腫是系統性血管炎的一組症候群還沒有一種滿意的診斷和分類方法1990年美國風濕病學會根據一項分析研究結果制定了一套診斷標準。該研究共收集了85例Wegner肉芽腫及722例其他形式的血管炎作為對照組。該標準主要有4項,診斷Wegner肉芽腫的敏感性為88%特異性為92%如果血管炎患者具有下述4項標準中的2項或2項以上就可診斷為Wegner肉芽腫:①鼻或口腔炎症;②胸部X線片異常;③尿沉澱異常;④活檢結果為肉芽腫性炎症鑑別Wegner肉芽腫和其他血管炎病的最佳指標是活檢呈現肉芽腫性炎症改變。然而這一診斷標準在套用中也存在一定的缺陷,因為在實驗組中有近12%的Wegner肉芽腫患者並未被診斷出此病(即假陰性)該項研究的最大缺點是在其診斷標準中沒有設立抗中性粒細胞胞漿自身抗體的相關內容,因為當時檢測此抗體的技術還未得到廣泛套用。
鑑別診斷
需要與Wegner肉芽腫相鑑別的疾病比較多,包括感染炎症性改變、腫瘤、結締組織疾病以及其他形式的血管炎。Wegner肉芽腫的多數眼科表現都具有非特異性。診斷明確的患者通常有周邊性角膜潰瘍、壞死性鞏膜炎或炎症性眼眶疾病。需要與Wegner肉芽腫相鑑別的疾病隨著受累組織的不同而有所變化。鑑別診斷也要根據不同情況而有異。
檢查
紅細胞
紅細胞pANCA對於診斷Wegner肉芽腫不是可靠的指標因為pANCA在某些需要與Wegner肉芽腫相鑑別的疾病中陽性率更高。抗髓過氧化物酶是顯微鏡下多動脈炎中最常見的自身抗體,它在結締組織疾病Churg-Strauss綜合徵(與哮喘和嗜酸性粒細胞增多有關的一種壞死性血管炎)、藥物引起的狼瘡和炎症性腸道疾病(尤其是潰瘍性結腸炎)中也可有規律地出現另一種“pANCA”,即抗乳鐵蛋白,可在20%的類風濕性血管炎患者和50% Felty綜合徵患者中出現陽性。
間接免疫螢光試驗是進行ANCA篩查的標準試驗。該技術利用正常外周血粒細胞或人白血病細胞作為底物並使用幾種常見動物來源之一的抗人螢光標記耦聯的抗體。該試驗的可靠性依賴於所用底物的類型、細胞的來源固定的方法、孵育和沖洗等技術國際研究小組“ANCA試驗標準基金會”提供了試驗參數和其與臨床確切關係的標準其他一系列檢測ANCA和特殊抗體亞型的試驗也得到發展包括酶聯免疫試驗(ELISA)、放射免疫試驗Western印跡試驗及免疫沉澱法。
這些技術主要是用於鑑別與cANCA,pANCN和非典型免疫螢光模式有關的特殊自身抗體。cANCA模式通常與單一抗原、蛋白酶-3有關,而pANCA與某些抗原如髓過氧化物酶、乳鐵蛋白、人白細胞彈性蛋白酶、溶酶體酶和細胞自溶酵素-G等有關。
治療
Wegner肉芽腫的病程長短取決於疾病的嚴重程度和治療情況初始,Wegner肉芽腫被視為一種進展迅速的致死性疾病。引起死亡的原因通常為腎功能衰竭或繼發性感染。糖皮質激素和細胞毒藥物能改善Wegner肉芽腫的預後,但同時也會引起嚴重的毒性和免疫抑制性副作用。糖皮質激素對Wegner肉芽腫的自然病程具有顯著影響但對生存率的影響卻不大,病變已累及全身的患者多數無法完全恢復。單純口服糖皮質激素並不能完全控制Wegner肉芽腫的嚴重眼部炎症。聯合使用環磷醯胺可明顯降低其死亡率,提高其生存率。但是細胞毒藥物對於進展期腎功能不全者則效果不良。
預後
直到20世紀70年代早期,此病的平均生存時間僅為5個月,1年內的死亡率為82%。在NIH研究中的158例Wegner肉芽腫患者通過每天環磷醯胺和糖皮質激素標準方案治療,75%得到緩解,90%以上顯著改善。許多患者在3個月內得到緩解,而另外一些患者則需要經過1~5年時間的治療此病易復發,發生率可高達50%
安全提示
Wegener肉芽腫(韋格納肉芽腫病,WegenerGranulomatosis,WG)是一種病因不明的血管性、系統性、炎症性疾病,臨床表現以呼吸道壞死性肉芽腫性炎症,局灶性壞死性腎小球腎炎和累及其它周身器官的血管炎為主要特徵。本病發病率較低,屬於非常見病,易誤診和漏診。Wegener肉芽腫年發病率為百萬分之0.5到8.5。另外8%~16%的Wegener肉芽腫患者以眼部為首發症狀,28%~87%的患者最終累及眼部。眼部表現可為鄰接型和灶型兩種。眼部表現包括嚴重眼眶假瘤,眼眶膿腫、蜂窩組織炎或者鼻淚管阻塞,其中眼眶炎症伴眼球突出是Wegener肉芽腫最常見的眼部表現。
 肉芽腫
肉芽腫